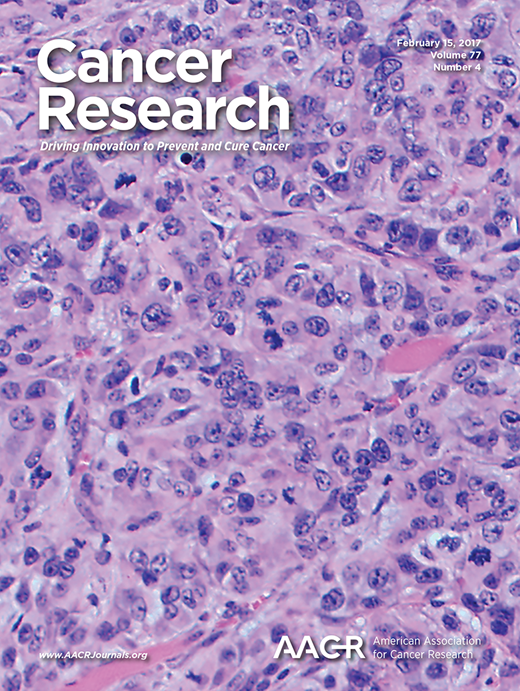
A Novel Mouse Model to Study Image-Guided, Radiation-Induced Intestinal Injury and Preclinical Screening of Radioprotectors

Research
Highlighted

Whole Abdominal Pencil Beam Scanned Proton FLASH Increases Acute Lethality
International Journal of Radiation Oncology*Biology*Physics
·
01 Feb 2025
·
doi:10.1016/j.ijrobp.2024.09.006

Orthovoltage X-Rays Exhibit Increased Efficacy Compared with γ-Rays in Preclinical Irradiation
Cancer Research
·
03 Aug 2022
·
doi:10.1158/0008-5472.CAN-22-0656
All
2025

Carbon Ion Therapy-Induced Local Control of Pancreatic Cancer is Dependent on the Presence of the Adaptive Anti-Tumor Immunity
International Journal of Radiation Oncology*Biology*Physics
·
01 Sep 2025
·
doi:10.1016/j.ijrobp.2025.06.2566

Understanding Vaccine Disparities in the Bronx, New York, Through a Mixed Methods Analysis of Community and Provider Perspectives
AJPM Focus
·
01 Aug 2025
·
doi:10.1016/j.focus.2025.100373
Loss of CARM1 alters the developmental programming of Glioma stem-like cells and creates a druggable NGFR/NTRK dependency
openRxiv
·
17 Apr 2025
·
doi:10.1101/2025.04.11.647869

FLASH proton reirradiation, with or without hypofractionation, reduces chronic toxicity in the normal murine intestine, skin, and bone
Radiotherapy and Oncology
·
01 Apr 2025
·
doi:10.1016/j.radonc.2025.110744

Whole Abdominal Pencil Beam Scanned Proton FLASH Increases Acute Lethality
International Journal of Radiation Oncology*Biology*Physics
·
01 Feb 2025
·
doi:10.1016/j.ijrobp.2024.09.006
2024

Immunological Effectiveness of Carbon Ion Radiotherapy in Pancreatic Cancer
International Journal of Radiation Oncology*Biology*Physics
·
01 Oct 2024
·
doi:10.1016/j.ijrobp.2024.07.2303

Validation and reproducibility of in vivo dosimetry for pencil beam scanned FLASH proton treatment in mice
Radiotherapy and Oncology
·
01 Sep 2024
·
doi:10.1016/j.radonc.2024.110404
Radiobiological Investigations of Orthovoltage X-Rays, FLASH Proton Therapy, and Carbon Ion Radiotherapy
Albert Einstein College of Medicine
·
18 Jul 2024
·
[no id info]

Thrombopoietin mimetic stimulates bone marrow vascular and stromal niches to mitigate acute radiation syndrome
Springer Science and Business Media LLC
·
19 Feb 2024
·
doi:10.21203/rs.3.rs-3946910/v1
Role of chemokine receptors in gastrointestinal mucosa
International Review of Cell and Molecular Biology
·
01 Jan 2024
·
doi:10.1016/bs.ircmb.2024.02.003
2023

Commissioning a 250 MeV research beamline for proton FLASH radiotherapy preclinical experiments
Medical Physics
·
29 Mar 2023
·
doi:10.1002/mp.16364
Radiosensitization beyond DNA damage: Monte Carlo simulations of realistic nanomaterial biodistributions
arXiv
·
01 Jan 2023
·
doi:10.48550/arXiv.2312.07688
2022

Preclinical models of radiation-induced cardiac toxicity: Potential mechanisms and biomarkers
Frontiers in Oncology
·
12 Oct 2022
·
doi:10.3389/fonc.2022.920867

Immune responses in COVID-19 and tuberculosis coinfection: A scoping review
Frontiers in Immunology
·
26 Aug 2022
·
doi:10.3389/fimmu.2022.992743

Orthovoltage X-Rays Exhibit Increased Efficacy Compared with γ-Rays in Preclinical Irradiation
Cancer Research
·
03 Aug 2022
·
doi:10.1158/0008-5472.CAN-22-0656
Acute and late effects of focal irradiation of the intestine using a novel volume-scaled mouse model
University of Pennsylvania
·
20 Jun 2022
·
[no id info]
Abstract 1319: Complement activation in pancreatic ductal adenocarcinoma
Cancer Research
·
15 Jun 2022
·
doi:10.1158/1538-7445.am2022-1319

A stromal Integrated Stress Response activates perivascular cancer-associated fibroblasts to drive angiogenesis and tumour progression
Nature Cell Biology
·
01 Jun 2022
·
doi:10.1038/s41556-022-00918-8

Rapid Mobilization of Medical Student Volunteers to Administer Vaccines During the COVID-19 Pandemic
Journal of Medical Education and Curricular Development
·
01 Jan 2022
·
doi:10.1177/23821205211073092
2019

Interleukin 6 Signaling Blockade Exacerbates Acute and Late Injury From Focal Intestinal Irradiation
International Journal of Radiation Oncology*Biology*Physics
·
01 Mar 2019
·
doi:10.1016/j.ijrobp.2018.10.007
2018

Assessing the Validity of Clinician Advice That Patients Avoid Use of Topical Agents Before Daily Radiotherapy Treatments
JAMA Oncology
·
01 Dec 2018
·
doi:10.1001/jamaoncol.2018.4292
2017
A Novel Mouse Model to Study Image-Guided, Radiation-Induced Intestinal Injury and Preclinical Screening of Radioprotectors
Cancer Research
·
14 Feb 2017
·
doi:10.1158/0008-5472.CAN-16-2724
